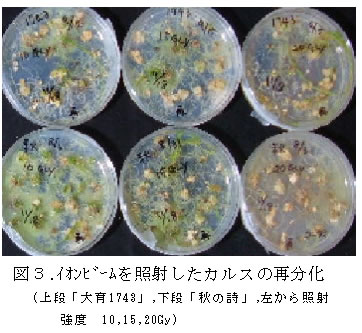

| [成果情報名] | 水稲「秋の詩」「大育 1743」の玄米や培養細胞へのイオンビーム照射適正線量 |
| [要約] | 水稲「秋の詩」と「大育1743」について炭素イオン(12C6+)のエネルギー320 Mev条件でイオンビームを照射する場合、玄米では発芽率と稔実率から見て20~80 Gyが適正で ある。また、培養細胞では再分化率や再分化本数から見ると10~20 Gyが適正である。 |
| [キーワード] | 水稲、玄米、培養細胞、イオンビーム |
| [担当] | 滋賀農技セ・先端技術開発部・生物工学担当 |
| [連絡先] | 電話番号 0748-46-3083、電子メール kitamura-harushige@pref.shiga.lg.jp |
| [区分] | 近畿中国四国農業・生物工学 |
| [分類] | 科学・参考 |
[具体的データ]

 |
|
| [その他] | ||
| 研究課題名 | : | バイオテクノロジーを利用した育種改良技術の開発 |
| 予算区分 | : | 県単 |
| 研究期間 | : | 2004~2007年度 |
| 研究担当者 | : | 北村治滋、森 真理、佐藤大祐、片山寿人、長谷純宏、田中 淳(日本原子力研究所) |
| 発表論文等 | : | 森ら (2005) 第3回イオンビーム生物応用研究ワークショップ論文集 25-27. 北村ら (2005) TIARA研究発表会要旨 68-69. |